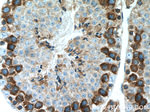
AARSD1 Antibody in Immunohistochemistry (Paraffin) (IHC (P))

Search
Proteintech
AARSD1 Polyclonal Antibody
{{$productOrderCtrl.translations['antibody.pdp.commerceCard.promotion.promotions']}}
{{$productOrderCtrl.translations['antibody.pdp.commerceCard.promotion.viewpromo']}}
{{$productOrderCtrl.translations['antibody.pdp.commerceCard.promotion.promocode']}}: {{promo.promoCode}} {{promo.promoTitle}} {{promo.promoDescription}}. {{$productOrderCtrl.translations['antibody.pdp.commerceCard.promotion.learnmore']}}
产品信息
14900-1-AP
种属反应
宿主/亚型
分类
类型
抗原
偶联物
形式
浓度
规格
纯化类型
保存液
内含物
保存条件
运输条件
产品详细信息
Immunogen sequence: TINDISVLR VTRRGEQADH FTQTPLDPGS QVLVRVDWER RFDHMQQHSG QHLITAVADH LFKLKTTSWE LGRFRSAIEL DTPSMTAEQV AAIEQSVNEK IRDRLPVNVR ELSLDDPEVE QVSGRGLPDD HAGPIRVVNI EGVDSNMCCG THVSNLSDLQ VIKILGTEKG KKNRTNLIFL SGNRVLKWME RSHGTEKALT ALLKCGAEDH VEAVKKLQNS TKILQKNNLN LLRDLAVHIA HSLRNSPDWG GVVILHRKEG DSEFMNIIAN EIGSEETLLF LTVGDEKGGG LFLLAGPPAS VETLGPRVAE VLEGKGAGKK GRFQGKATKM SRRMEAQALL QDYISTQSAK E (176-525 aa encoded by BC004172)
靶标信息
AARSD1 functions in trans to edit the amino acid moiety from incorrectly charged tRNA(Ala).
仅用于科研。不用于诊断过程。未经明确授权不得转售。
篇参考文献 (0)
生物信息学
蛋白别名: Alanyl-tRNA deacylase alaX; Alanyl-tRNA editing protein Aarsd1; Alanyl-tRNA synthetase domain-containing protein 1; AlaX; MGC2744
基因别名: 1110069E20Rik; 2310044P18Rik; AA589600; AARSD1; AlaX; AlaXp; AlaXp-II
UniProt ID: (Human) Q9BTE6, (Rat) Q5XI97, (Mouse) Q3THG9
Entrez Gene ID: (Human) 80755, (Rat) 619440, (Mouse) 69684